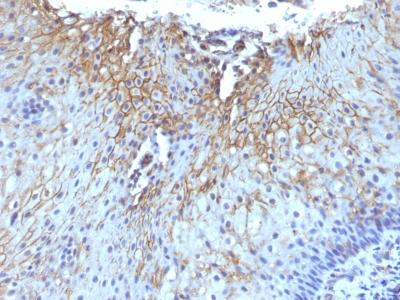

Monoclonal Antibody to CD59 / Complement Regulatory Protein / Protectin(Clone : SPM616)
Figure-1: Formalin-fixed, paraffin-embedded human Tongue stained with CD59 Monoclonal Antibody (SPM616)
Roll over image to zoom in
Shipping Info:
For estimated delivery dates, please contact us at [email protected]
Format : | Purified |
Amount : | 100 µg |
Isotype : | Mouse IgG1, kappa |
Purification : | Affinity Chromatography |
Content : | 100 µg in 500 µl PBS containing 0.05% BSA and 0.05% sodium azide. Sodium azide is highly toxic. |
Storage condition : | Store the antibody at 4°C; stable for 6 months. For long-term storage; store at -20°C. Avoid repeated freeze and thaw cycles. |
Reacts with human CD59, a 20kDa glycosyl phosphatidyl-inositol (GPI)-anchored cell surface protein. CD59 regulates complement-mediated cell lysis, and it is involved in lymphocyte signal transduction. This protein is a potent inhibitor of the complement membrane attack complex, whereby it binds complement C8 and/or C9 during the assembly of this complex, thereby inhibiting the incorporation of multiple copies of C9 into the complex, which is necessary for osmolytic pore formation. It inhibits formation of MAC, thus protecting cells from complement-mediated lysis. Genetic defects in GPI-anchor attachment, that cause a reduction or loss of CD59 and CD55 on erythrocytes produce the symptoms of the disease paroxysmal hemoglobinuria (PNH). This MAb is useful for study on GPI-anchored proteins, PNH and CD59 functions. CD59 is widely distributed on cells in all tissues. The expression of CD59 on erythrocytes is important for their survival.
Functional Studies (Order Ab without Azide); Flow Cytometry (1-2ug/million cells); Immunofluorescence (1-2ug/ml); Immunohistochemistry (Formalin-fixed) (1-2ug/ml for 30 minutes at RT)(Staining of formalin-fixed tissues requires heating tissue sections in 10mM Tris with 1mM EDTA, pH 9.0, for 45 min at 95°C followed by cooling at RT for 20 minutes);
For Research Use Only. Not for use in diagnostic/therapeutics procedures.
Subcellular location: | Cell membrane, Secreted |
Post transnational modification: | Glycated. Glycation is found in diabetic subjects, but only at minimal levels in nondiabetic subjects. Glycated CD59 lacks MAC-inhibitory function and confers to vascular complications of diabetes. |
BioGrid: | 107404. 37 interactions. |
There are currently no product reviews
|